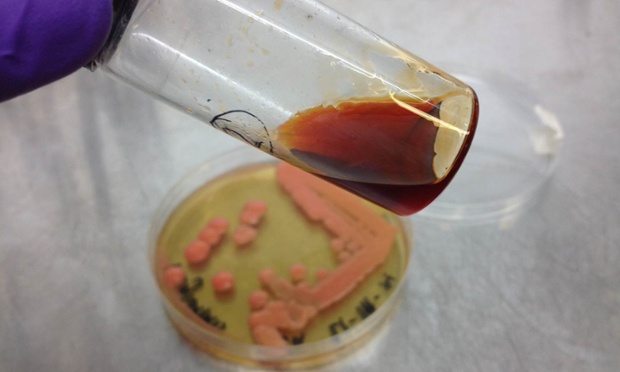
M pulcherrim

Day 279: Yeast revealed as alternative to palm oil

2nd March 2015
Author: Geoff Maitland, IChemE President 2014–2015.
The oil palm is a very productive crop, and that's why the two biggest producers of palm oil, Indonesia and Malaysia, can produce and process around 20 million tonnes each per year.
But, palm oil production attracts criticism the world over. Deforestation and the destruction of natural habitats, such as tropical rain forests, are some of the detrimental effects of palm oil plantations.
Palm oil has some very desirable properties, including an exceptionally high melting point and high saturation levels, so it's easy to see why the palm oil industry isn't slowing down, despite environmental and sustainability issues.
Researchers at the University of Bath, UK may have discovered a revolutionary palm oil substitute - yeast.

The specific yeast in question is Metschnikowia pulcherrima, and it is best known for its use in South Africa's wine industry.
Researchers from Bath's chemical engineering and biochemistry departments have been collaborating though a three-year research programme that examines the potential of yeast as an alternative to palm oil.
They have successfully cultivated an oily yeast that has properties that match those of palm oil, with early tests showing that M. pulcherrima can produce up to 20 grams per litre of oil.
The yeast produces a lipid with a similar profile to palm oil and it has the ability to grow on practically any organic feed stock. This means that many organic wastes now have the potential to be recycled.
Dr Chris Chuck, from the department of Chemical Engineering, and Professor Rod Scott, from the department of Biology and Biochemistry, are leading the project in the university's Centre for Sustainable Chemical Technologies.
Chris said: “Irrespective of what you are putting in at the start, whether it’s rapeseed, straw or waste food, M. pulcherrima can use the sugars in it and grow on it.”
He also estimates that the land use requirement for commercial yeast production could be 10 or even up to 100 times less than that required for palm oil, which would mean a significantly reduced carbon footprint.
Tests have shown that M. pulcherrima is very tolerant to inhibitors, which means that it can grow in pH levels ranging from 1.9 to 9.0 and at temperatures ranging from 12 - 30°C.
The researchers have also found that the feed doesn't need to be broken down into sugars first by adding enzymes - which would be very costly.
Over the coming months, the team will be scaling up their yeast-based process in bioreactors with a 30 - 50 litre capacity and they aim to expand the capacity further to 10,000 litres by the end of the year. Commercial expansion and production could be reached in as little as three to four years; a prospect that has attracted industry funding.
It's clear to see that this work has the potential to make a positive global impact and to address the deforestation issue. So I congratulate them on this exciting breakthrough and wish them every success on bringing the process to market.
If you are working with yeast or biofuels, why not get in touch and let me know where your research is heading?
ChemEng365 blog
Geoff Maitland launched this blog during his IChemE presidency in 2014. ChemEng365 features 365 chemical engineering successes and achievements throughout his year-long presidency.